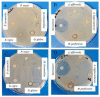
Figure 1

Bulgarian Medicinal Extracts as Natural Inhibitors with Antiviral and Antibacterial Activity
- PMID: 35807618
- PMCID: PMC9268788
- DOI: 10.3390/plants11131666
Bulgarian Medicinal Extracts as Natural Inhibitors with Antiviral and Antibacterial Activity
Abstract
Background: Bulgaria is a country with a wide range of medicinal plants, with uses in traditional medicine dating back for centuries.
Methods: Disc diffusion assay was used to evaluate the antimicrobial activity of the plant extracts. A cytopathic effect inhibition test was used for the assessment of the antiviral activity of the extracts. The virucidal activity of the extracts, their influence on the stage of viral adsorption, and their protective effect on uninfected cells were reported using the end-point dilution method, and Δlgs was determined as compared to the untreated controls.
Results: The results of the study reveal that the antibacterial potential of G. glabra and H. perforatum extracts in Gram-positive bacteria is more effective than in Gram-negative bacteria. When applied during the replication of HSV-1 and HCov-OC-43, only some of the extracts showed weak activity, with SI between 2 to 8.5. Almost all tested extracts inhibited the extracellular virions of the studied enveloped viruses (HSV-1 and HCov-OC-43) to a greater extent than of the non-enveloped viruses (PV-1 and HAdV-5). They inhibited the stage of viral adsorption (HSV-1) in the host cell (MDBK) to varying degrees and showed a protective effect on healthy cells (MDBK) before they were subjected to viral invasion (HSV-1).
Conclusion: The antipathogenic potential of extracts of H. perforatum and G. glabra suggests their effectiveness as antimicrobial agents. All 13 extracts of the Bulgarian medicinal plants studied can be used to reduce viral yield in a wide range of viral infections.
Keywords: antimicrobial activity; herpes simplex virus-1; human adenovirus-5; human coronavirus; natural extracts; poliovirus-1; viral adsorption; virucidal activity.
Conflict of interest statement
The authors declare no conflict of interest. The sponsors had no role in the design, execution, interpretation, or writing of the study.
Figures
References
-
- Stoitsova S., Paunova-Krasteva T., Borisova D. Modulation of Biofilm Growth by Sub-Inhibitory Amounts of Antibacterial Substances. In: Dhanasekaran D., Thajuddin N., editors. Microbial Biofilms—Importance and Applications. IntechOpen; London, UK: 2016. pp. 441–462.
-
- Poli J.P., Guinoiseau E., De Rocca Serra D., Sutour S., Paoli M., Tomi F., Quilichini Y., Berti L., Lorenzi V. Anti-quorum sensing activity of 12 essential oils on chromobacterium violaceum and specific action of cis-cis-p-menthenolide from corsican Mentha suaveolens ssp. Insularis. Molecules. 2018;23:2125. doi: 10.3390/molecules23092125. - DOI - PMC - PubMed
Grants and funding
LinkOut - more resources
Full Text Sources

